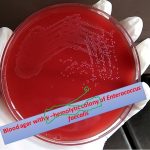
Blood agar
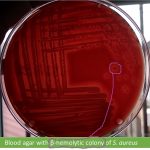
Blood agar
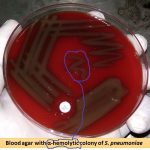
Blood agar

Collection Group: Clinical Bacteriology
Blood agar with gamma hemolytic colony: Enterococci and their detail
Gamma hemolytic colony 5% sheep blood agar (BAP) is with...
Gamma hemolytic colony 5% sheep blood agar (BAP) is with...
Blood agar showing beta hemolytic colony: Introduction, Possible organism and its details
Introduction 5% sheep blood agar is with beta (β) hemolytic...
Introduction 5% sheep blood agar is with beta (β) hemolytic...
Blood agar with alpha hemolytic colony: Introduction, Possible pathogen and its details
Introduction 5% sheep blood agar(BAP) is with growth of Streptococcus...
Introduction 5% sheep blood agar(BAP) is with growth of Streptococcus...
